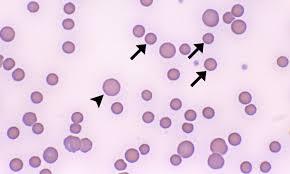
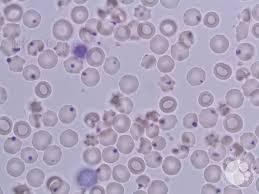

What is a complication of chronic anemia?
High cardiac output failure
After diagnosing anemia either with a low hematocrit or low hemoglobin what is the next step in managment to determine the kind of anemia?
MCV
Normal MCV
80-100
What is the heme component of hemoglobin ?
portyprhrin and Fe
What is the globin component of hemoglobin?
Alpha and Beta proteins
What laboratory value should be checked in a patient with anemia (low hematocrit or hemoglobin), but a normal MCV?
Reticulocyte
Patient with anemia with a normal MCV either are anemic because increased _______ or reduced ______ of RBC’s
Destruction or production
What labs would we reference in order to differentiate, between intravascular and extravascular hemolysis?
Haptoglobin, LDH, Bilirubin, Hemoglobin in the Urine.
What would haptoglobin, LDH, bilirubin, hemoglobin in the urine look like in a patient with intravascular hemolysis in comparison with extravascular hemolysis.
Haptoglobin: low
LDH: high
Bilirubin: high
Hemglobinuria: present
splenomegaly: absent
What would haptoglobin, LDH, bilirubin, hemoglobin in the urine look like in a patient with extravascular hemolysis.
Haptglobin: normal to low
LDH: normal to high
Bilirubin: high
Hemoglobinuria: absent
splenomegaly: present
What are the causes of cold autoimmune hemolytic anemia
Mycoplasma pneumonia, EBV, WM, and lymphomas
What are the causes of warm hemolytic anemia?
SLE, drugs that cause SLE like symptoms, hemolytic anemia of a newborn.
A coomb’s test would be positive in autoimmune hemolytic anemias, what are the differences in the coomb’s test between warm and cold?
Cold: c3b and warm: Anti-G
What is the best screening test for spherocytosis?
eosin- 5 malemide, osmotic fragility test, acidified glycerol lysis, cryohemolysis
What does the blood smear show?
RBC’s w/o central pallor, which can be spherocytes, or autoimmune hemolytic anemia
What is the difference between autoimmune hemolytic anemia and spherocytosis?
Spherocytosis will be negative for Coomb’s. Although they correlate with most everything else. with IgG antibodies and being extravasular hemolysis
What are risk factors for G6PD
Drugs like sulfamethazole, primaquine, quinine, dapsone, isoniazid, and rifampin and fava beans
How do we diagnose G6PD
G6PD enzyme assay
What does this blood smear show?
Heinz bodies
What kind of anemias hemolyze intravascularly?
PNH, Cold agglutinins, G6PD, (also TTP, HUS, DIC)
What kind of anemias hemolyze extravascullarly?
Spherocytes, warm agglutinins,
What laboratory value should be checked in a patient with a MCV >100?
Folate or B12
A patient presents with to your office with complaints fatigue and of dark urine upon waking in the morning. What is the pathology behind this patients dark urine?
The patient has a genetic defect that makes his RBC membrane (PIG-A), which stands for decay acceelerating factor (CD55 and 59). In acidic environments are RBC’s become more susceptible (night time).
What is the most common cause of death in a patient with paroxysmal nocturnal hemoglobinuria?
Thrombosis








